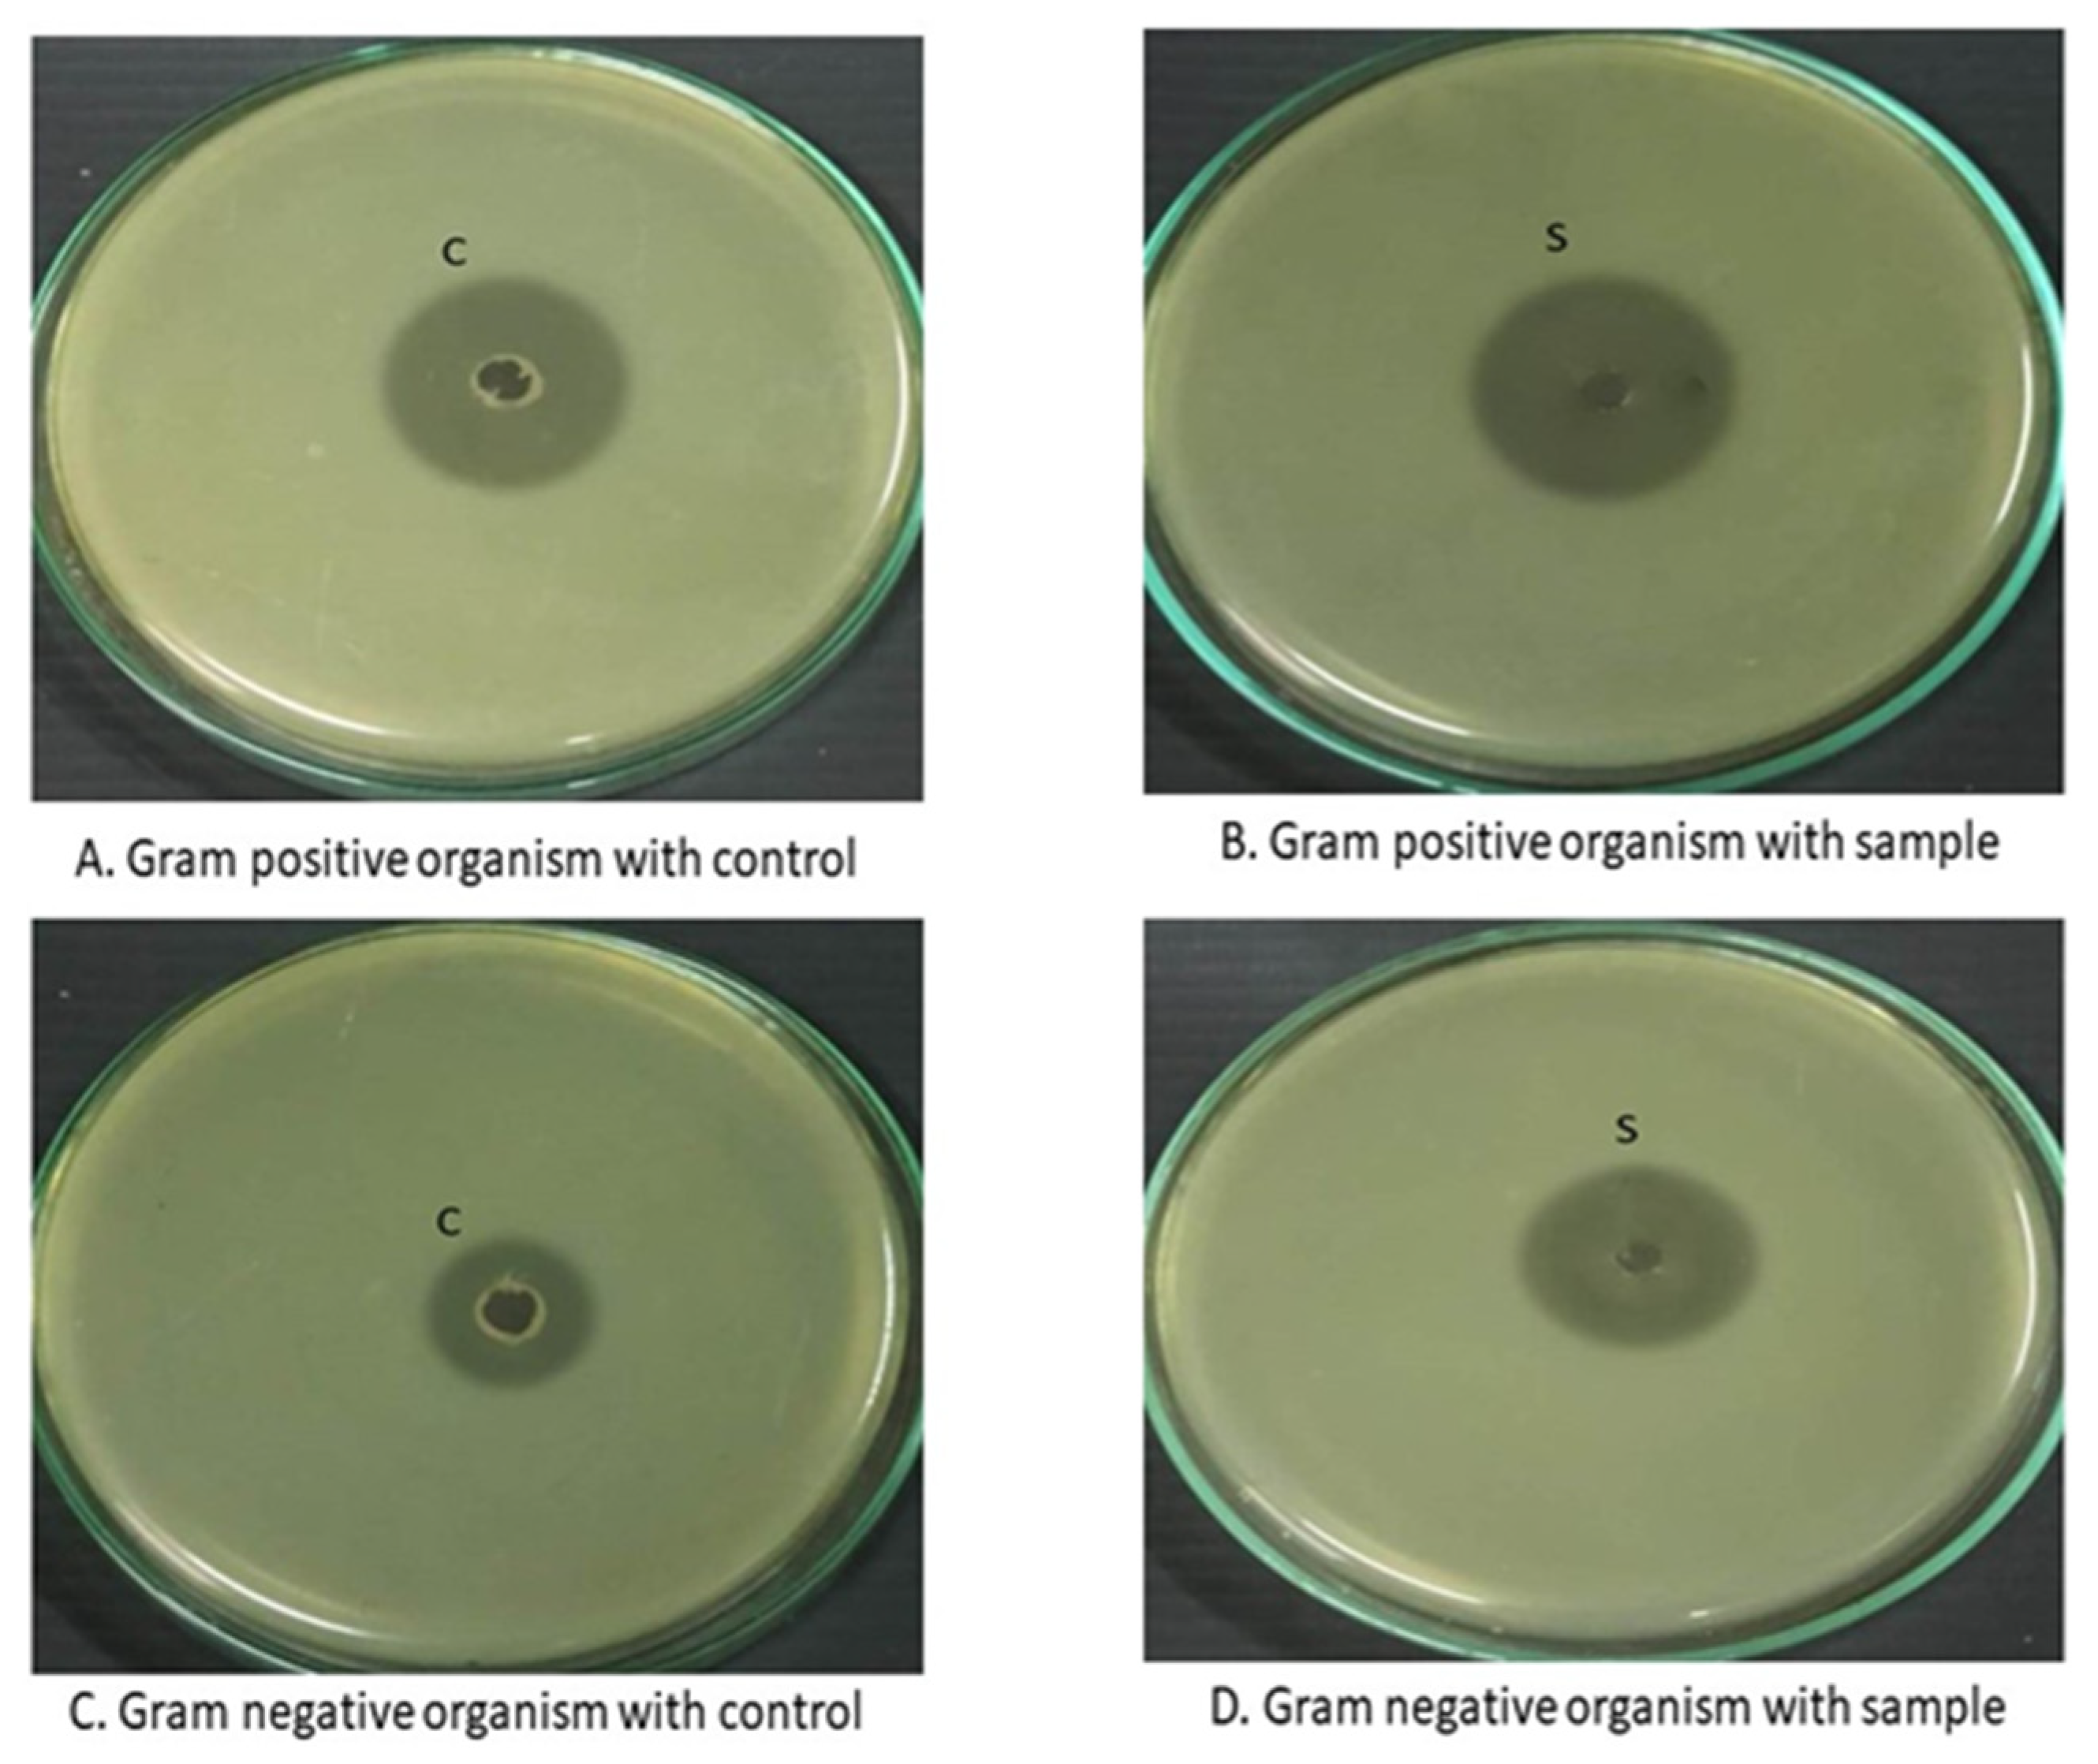

Formulation and Evaluation of pH-Modulated Amorphous Solid Dispersion-Based Orodispersible Tablets of Cefdinir
Abstract
1. Introduction
2. Materials and Methods
2.1. Materials
2.2. Phase Solubility Study
2.3. Preparation of Solid Dispersion
2.4. Characterization of Solid Dispersion
2.4.1. Saturation Solubility Study
2.4.2. In Vitro Release Challenge Studies
2.4.3. Fourier Transform Infrared Spectroscopy
2.4.4. Differential Scanning Calorimetric Analysis
2.4.5. Powder X-ray Diffraction Study
2.4.6. Scanning Electron Microscopy
2.4.7. Antimicrobial Assay
2.5. Formulation of Porous Orodispersible Tablets
2.6. Evaluation of Pre-Compression Properties
2.7. Evaluation of Rapid Orodispersible Tablets
2.7.1. Weight Variation
2.7.2. Hardness
2.7.3. Thickness
2.7.4. Friability
2.7.5. Content Uniformity
2.7.6. Wetting Time and Water Absorption Test
2.7.7. Disintegration Test
2.7.8. In Vitro Release Challenge Studies
2.7.9. Stability Studies
2.8. Statistical Analysis
3. Results
3.1. pH Solubility Profiling
3.2. Phase Solubility Study
3.3. Formulation of Solid Dispersion of Cefdinir
3.4. Characterization of Solid Dispersion of Cefdinir
3.4.1. Saturation Solubility Studies of Solid Dispersion
3.4.2. In Vitro Release Challenge Study of Solid Dispersion of Cefdinir
3.4.3. Fourier Transform Infrared Analysis
3.4.4. Differential Scanning Calorimetry
3.4.5. X-ray Powder Diffraction
3.4.6. Scanning Electron Microscopy
3.4.7. Antimicrobial Studies
3.5. Formulation of the Orodispersible Tablets
Pre-Compression Tests
3.6. Evaluation of Orodispersible Tablets
3.6.1. Post-Compression Parameters
3.6.2. In Vitro Release Challenge Studies
3.6.3. Stability Studies
4. Discussion
5. Conclusions
Author Contributions
Funding
Institutional Review Board Statement
Informed Consent Statement
Data Availability Statement
Acknowledgments
Conflicts of Interest
References
- Lim, W.S. Pneumonia—Overview. In Encyclopedia of Respiratory Medicine; Elsevier: Amsterdam, The Netherlands, 2022; pp. 185–197. [Google Scholar] [CrossRef]
- Feldman, C.; Anderson, R. Pneumonia as a systemic illness. Curr. Opin. Pulm. Med. 2018, 24, 237–243. [Google Scholar] [CrossRef]
- Hayes, B.H.; Haberling, D.L.; Kennedy, J.L.; Varma, J.K.; Fry, A.M.; Vora, N.M. Burden of pneumonia-associated hospitalizations: United States, 2001–2014. Chest 2018, 153, 427–437. [Google Scholar] [CrossRef]
- Prina, E.; Ranzani, O.T.; Torres, A. Community-acquired pneumonia. Lancet 2015, 386, 1097–1108. [Google Scholar] [CrossRef]
- Cillóniz, C.; Rodríguez-Hurtado, D.; Torres, A. Characteristics and management of community-acquired pneumonia in the era of global aging. Med. Sci. 2018, 6, 35. [Google Scholar] [CrossRef]
- Watkins, R.R.; Van Duin, D. Current trends in the treatment of pneumonia due to multidrug-resistant Gram-negative bacteria. F1000Research 2019, 8, 121. [Google Scholar] [CrossRef]
- Cho, H.J.; Jee, J.P.; Kang, J.Y.; Shin, D.Y.; Choi, H.G.; Maeng, H.J.; Cho, K.H. Cefdinir solid dispersion composed of hydrophilic polymers with enhanced solubility, dissolution, and bioavailability in rats. Molecules 2017, 22, 280. [Google Scholar] [CrossRef]
- Sawant, K.K.; Patel, M.H.; Patel, K. Cefdinir nanosuspension for improved oral bioavailability by media milling technique: Formulation, characterization and in vitro–in vivo evaluations. Drug. Dev. Ind. Pharm. 2016, 42, 758–768. [Google Scholar] [CrossRef]
- Jung, D.H.; Song, J.G.; Han, H.K. Development and evaluation of a sustained release solid dispersion of cefdinir using a hydrophobic polymeric carrier and aminoclay. J. Drug. Deliv. Sci. Technol. 2023, 84, 104503. [Google Scholar] [CrossRef]
- Aleem, O.; Kuchekar, B.; Pore, Y.; Late, S. Effect of β-cyclodextrin and hydroxypropyl β-cyclodextrin complexation on physicochemical properties and antimicrobial activity of cefdinir. J. Pharm. Biomed. Anal. 2008, 47, 535–540. [Google Scholar] [CrossRef]
- Morina, D.; Sessevmez, M.; Sinani, G.; Mülazımoğlu, L.; Cevher, E. Oral tablet formulations containing cyclodextrin complexes of poorly water soluble cefdinir to enhance its bioavailability. J. Drug. Deliv. Sci. Technol. 2020, 57, 101742. [Google Scholar] [CrossRef]
- Praveen, R.; Singh, S.K.; Verma, P.R. Pharmacokinetic evaluation of cefdinir-loaded floating alginate beads in rabbits using LC–MS/MS. J. Pharm. Investig. 2016, 46, 283–291. [Google Scholar] [CrossRef]
- Badawy, S.I.F.; Hussain, M.A. Microenvironment pH modulation in solid dosage form. J. Pharm Sci. 2007, 96, 948–959. [Google Scholar] [CrossRef]
- Powers, J.L.; Gooch, W.M., III; Oddo, L.P. Comparison of the palatability of the oral suspension of cefdinir vs. amoxicillin/clavulanate potassium, cefprozil and azithromycin in pediatric patients. J. Pediatr. Infect. Dis. 2000, 19, S174–S180. [Google Scholar] [CrossRef]
- Sakure, K.; Kumari, L.; Badwaik, H. Development and evaluation of solid dispersion based rapid disintegrating tablets of poorly water-soluble anti-diabetic drug. J. Drug. Deliv. Sci. Technol. 2020, 60, 101942. [Google Scholar] [CrossRef]
- Tarani, E.; Arvanitidis, I.; Christofilos, D.; Bikiaris, D.N.; Chrissafis, K.; Vourlias, G. Calculation of the degree of crystallinity of HDPE/GNPs nanocomposites by using various experimental techniques: A comparative study. J. Mater. Sci. 2023, 58, 1621–1639. [Google Scholar] [CrossRef]
- Abd, E.R.S.; Shazly, G.A. Propafenone HCl fast dissolving tablets containing subliming agent prepared by direct compression method. Saudi. Pharm. J. 2017, 25, 1086–1092. [Google Scholar] [CrossRef]
- Sarraguca, M.C.; Cruz, A.V.; Soares, S.O.; Amaral, H.R.; Costa, P.C.; Lopes, J.A. Determination of flow properties of pharmaceutical powders by near infrared spectroscopy. J. Pharm. Biomed. Anal. 2010, 52, 484–492. [Google Scholar] [CrossRef]
- Government of India. Indian Pharmacopoeia; Controller of Publications; Government of India: Delhi, India, 2018; Volume II, pp. 1143–1144.
- Brniak, W.; Jachowicz, R.; Krupa, A.; Skorka, T.; Niwinski, K. Evaluation of co-processed excipients used for direct compression of orally disintegrating tablets (ODT) using novel disintegration apparatus. Pharm. Dev. Technol. 2013, 18, 464–474. [Google Scholar] [CrossRef]
- Yıldız, S.; Aytekin, E.; Yavuz, B.; Bozdağ Pehlivan, S.; Ünlü, N. Formulation studies for mirtazapine orally disintegrating tablets. Drug Dev. Ind. Pharm. 2016, 42, 1008–1017. [Google Scholar] [CrossRef]
- Bhujbal, S.V.; Mitra, B.; Jain, U.; Gong, Y.; Agrawal, A.; Karki, S.; Taylor, L.S.; Kumar, S.; Zhou, Q.T. Pharmaceutical amorphous solid dispersion: A review of manufacturing strategies. Acta Pharm. Sin. B 2021, 11, 2505–2536. [Google Scholar] [CrossRef]
- Shivakumar, H.N.; Desai, B.G.; Pandya, S.; Karki, S.S. Influence of β-cyclodextrin complexation on glipizide release from hydroxypropyl methylcellulose matrix tablets. PDA J. Pharm. Sci. Technol. 2007, 61, 472–491. [Google Scholar]
- Zhong, L.; Zhu, X.; Yu, B.; Su, W. Influence of alkalizers on dissolution properties of telmisartan in solid dispersions prepared by cogrinding. Drug Dev. Ind. Pharm. 2014, 40, 1660–1669. [Google Scholar] [CrossRef]
- Tran, P.H.L.; Tran, H.T.T.; Lee, B.-J. Modulation of microenvironmental pH and crystallinity of ionizable telmisartan using alkalizers in solid dispersions for controlled release. J. Cont. Rel. 2008, 129, 59–65. [Google Scholar] [CrossRef]
- Huang, Y.; Dai, W.G. Fundamental aspects of solid dispersion technology for poorly soluble drugs. Acta Pharm. Sin. B 2014, 4, 18–25. [Google Scholar] [CrossRef]
- Zhang, S.; Xu, X.; Sun, W.; Zhang, Z.; Pan, B.; Hu, Q. Enteric and hydrophilic polymers enhance dissolution and absorption of poorly soluble acidic drugs based on micro-environmental pH-modifying solid dispersion. Eur. J. Pharm. Sci. 2022, 168, 106074. [Google Scholar] [CrossRef]
- Mohit, V.; Harshal, G.; Neha, D.; Vilasrao, K.; Rajashree, H. Effect of preparation method on complexation of Cefdinir with β-cyclodextrin. J. Incl. Phenom. Macrocycl. Chem. 2010, 67, 39–47. [Google Scholar] [CrossRef]
- Mesallati, H.; Umerska, A.; Paluch, K.J.; Tajber, L. Amorphous polymeric drug salts as ionic solid dispersion forms of ciprofloxacin. Mol. Pharm. 2017, 14, 2209–2223. [Google Scholar] [CrossRef]
- Emery, E.; Oliver, J.; Pugsley, T.; Sharma, J.; Zhou, J. Flowability of moist pharmaceutical powders. Powder Technol. 2009, 189, 409–415. [Google Scholar] [CrossRef]
- Song, H.; Moon, C.; Lee, B.J.; Oh, E. Mesoporous pravastatin solid dispersion granules incorporable into orally disintegrating tablets. J. Pharm. Sci. 2018, 107, 1886–1895. [Google Scholar] [CrossRef]
- Shivakumar, H.N.; Desai, B.G.; Murthy, S.N.; Sharma, A. The disintegrative and dissolution of nabumetene dispersible tablets. Pharm. Technol. Int. 2007, 31, 60–69. [Google Scholar]
- Mistry, P.; Batchelor, H. Evidence of acceptability of oral paediatric medicines: A review. J. Pharm. Pharmacol. 2017, 69, 361–376. [Google Scholar] [CrossRef] [PubMed]
- Rojas, J.; Guisao, S.; Ruge, V. Functional assessment of four types of disintegrants and their effect on the spironolactone release properties. AAPS PharmSciTech 2012, 13, 1054–1062. [Google Scholar] [CrossRef] [PubMed]
- Eisa, A.M.; El-Megrab, N.A.; El-Nahas, H.M. Formulation and evaluation of fast dissolving tablets of haloperidol solid dispersion. Saudi Pharm. J. 2022, 30, 1589–1602. [Google Scholar] [CrossRef] [PubMed]
- Zaborenko, N.; Shi, Z.; Corredor, C.C.; Smith-Goettler, B.M.; Zhang, L.; Hermans, A.; Neu, C.M.; Alam, M.A.; Cohen, M.J.; Lu, X.; et al. First-principles and empirical approaches to predicting in vitro dissolution for pharmaceutical formulation and process development and for product release testing. AAPS J. 2019, 21, 32. [Google Scholar] [CrossRef] [PubMed]

| FORMULATION | DRUG | PVP K30 | PEG 6000 | MEGLUMINE | SODIUM BICARBONATE |
|---|---|---|---|---|---|
| SD1 | 200 | 100 | - | - | - |
| SD2 | 200 | 200 | - | - | - |
| SD3 | 200 | - | 100 | - | - |
| SD4 | 200 | - | 200 | - | - |
| ASD1 | 200 | 100 | - | - | 17 |
| ASD2 | 200 | 200 | - | - | 17 |
| ASD3 | 200 | 100 | - | 17 | - |
| ASD4 | 200 | 200 | - | 17 | - |
| ASD5 | 200 | - | 100 | - | 17 |
| ASD6 | 200 | - | 200 | - | 17 |
| ASD7 | 200 | - | 100 | 17 | - |
| ASD8 | 200 | - | 200 | 17 | - |
| Ingredients (mg) | F1 | F2 | F3 | F4 | F5 | F6 | F7 | F8 |
|---|---|---|---|---|---|---|---|---|
| CEF | 50 | 50 | - | - | - | - | - | - |
| ASD8 | - | - | 100 | 100 | 100 | 100 | 100 | 100 |
| Mannitol * | 57 | 67 | 11 | 11 | 11 | 15 | 15 | 15 |
| Microcrystalline cellulose * | 3 | - | - | 3 | 9 | 6 | 3 | 3 |
| Croscarmellose sodium | 15 | 15 | 15 | 15 | 15 | 15 | 15 | 15 |
| Crospovidone | 12 | 15 | 2 | 5 | 8 | 12 | 14 | 16 |
| Ammonium bicarbonate | 10 | - | 10 | 10 | 10 | - | - | - |
| Magnesium stearate | 2 | 2 | 2 | 2 | 2 | 2 | 2 | 2 |
| Talc | 1 | 1 | 1 | 1 | 1 | 1 | 1 | 1 |
| Solubilizer | Slope (sl) | Intercept | 1 − sl | Int (1 − sl) | Ks (L·g−1) |
|---|---|---|---|---|---|
| PVP K30 | 0.0883 | 5.072 | 0.912 | 4.625664 | 0.019024 |
| PEG 6000 | 0.0971 | 5.153 | 0.903 | 4.655868 | 0.020834 |
| Soluplus® | 0.079 | 4.977 | 0.921 | 4.583817 | 0.017235 |
| Formulation Code | Bulk Density (gm/cm3) | Tapped Density (gm/cm3) | Hausner’s Ratio | Carr’s Index | Angle of Repose |
|---|---|---|---|---|---|
| F1 | 0.553 ± 0.03 | 0.63 ± 0.03 | 1.13 ± 0.04 | 12.02 ± 0.89 | 21.65 ± 2.05 |
| F2 | 0.564 ± 0.05 | 0.65 ± 0.02 | 1.15 ± 0.03 | 14.28 ± 1.12 | 20.21 ± 2.26 |
| F3 | 0.562 ± 0.006 | 0.64 ± 0.01 | 1.08 ± 0.02 | 7.79 ± 1.65 | 21.56 ± 3.17 |
| F4 | 0.503 ± 0.015 | 0.60 ± 0.01 | 1.06 ± 0.01 | 7.57 ± 0.76 | 20.18 ± 2.21 |
| F5 | 0.543 ± 0.015 | 0.59 ± 0.015 | 1.05 ± 0.02 | 7.93 ± 0.54 | 19.92 ± 2.05 |
| F6 | 0.551 ± 0.01 | 0.62 ± 0.01 | 1.11 ± 0.07 | 7.98 ± 0.32 | 21.23 ± 1.24 |
| F7 | 0.563 ± 0.005 | 0.58 ± 0.01 | 1.07 ± 0.01 | 7.95 ± 0.23 | 21.70 ± 1.55 |
| F8 | 0.552 ± 0.01 | 0.61 ± 0.01 | 1.09 ± 0.015 | 8.02 ± 0.28 | 21.62 ± 2.03 |
| Formulation Code | Weight Variation (mg) | Hardness (Kg) | Thickness (mm) | %Friability | %Content Uniformity | Wetting Time (s) | Disintegration Time (s) | %Water Absorption Ratio |
|---|---|---|---|---|---|---|---|---|
| F1 | 150 ± 1.73 | 3.41 ± 0.25 | 2.75 ± 0.04 | 0.25 ± 0.04 | 89.12 ± 1.23 | 22.12 ± 1.25 | 45.46 ± 3.23 | 24.2 ± 1.4 |
| F2 | 150 ± 1.32 | 3.37 ± 0.28 | 2.79 ± 0.03 | 0.28 ± 0.07 | 88.32 ± 1.24 | 23.22 ± 1.54 | 40.89 ± 2.27 | 26.4 ± 1.5 |
| F3 | 151 ± 1.67 | 3.50 ± 0.25 | 3.02 ± 0.02 | 0.26 ± 0.05 | 88.82 ± 1.14 | 18.14 ± 1.31 | 32.41 ± 4.06 | 20.1 ± 1.37 |
| F4 | 149 ± 1.29 | 3.22 ± 0.24 | 3.01 ± 0.01 | 0.29 ± 0.09 | 93.34 ± 1.24 | 19.11 ± 1.29 | 30.25 ± 1.15 | 18.9 ± 2.33 |
| F5 | 150 ± 1.23 | 3.12 ± 0.28 | 2.99 ± 0.03 | 0.25 ± 0.04 | 96.46 ± 0.84 | 17.21 ± 1.79 | 27.11 ± 1.06 | 19.1 ± 2.24 |
| F6 | 148 ± 1.26 | 3.32 ± 0.21 | 3.05 ± 0.06 | 0.26 ± 0.05 | 90.14 ± 1.05 | 20.11 ± 2.58 | 34.45 ± 2.06 | 20.51 ± 1.26 |
| F7 | 152 ± 1.8 | 3.46 ± 0.14 | 3.01 ± 0.04 | 0.27 ± 0.06 | 90.12 ± 1.12 | 20.42 ± 1.89 | 33.45 ± 3.65 | 19.72 ± 1.76 |
| F8 | 147 ± 1.3 | 3.32 ± 0.18 | 3.02 ± 0.03 | 0.28 ± 0.07 | 91.10 ± 1.15 | 21.32 ± 1.33 | 37.34 ± 8.23 | 22.11 ± 1.15 |
| Evaluation Parameters | Initial | 25 ± 2 °C/60 ± 5%RH | 40 ± 2 °C/75 ± 5%RH | ||||
|---|---|---|---|---|---|---|---|
| 0-Month | 1-Month | 2-Month | 3-Month | 1-Month | 2-Month | 3-Month | |
| Average weight (mg) | 150 ± 1.23 | 150.01 ± 1.21 | 150.02 ± 1.24 | 150.02 ± 1.26 | 149.8 ± 1.27 | 149.6 ± 1.46 | 149.5 ± 1.16 |
| Hardness (kg/cm2) | 3.12 ± 0.28 | 3.1 ± 0.23 | 3.1 ± 0.22 | 3.1 ± 0.27 | 3.02 ± 0.25 | 3.05 ± 0.28 | 3.06 ± 0.22 |
| Friability (%) | 0.25 ± 0.04 | 0.25 ± 0.02 | 0.24 ± 0.06 | 0.24 ± 0.03 | 0.24 ± 0.03 | 0.24 ± 0.06 | 0.23 ± 0.05 |
| Drug content (%) | 96.46 ± 0.84 | 96.11 ± 0.86 | 96.10 ± 0.83 | 96.09 ± 0.87 | 95.38 ± 0.79 | 95.45 ± 0.97 | 95.52 ± 0.89 |
| Disintegration time (s) | 27.11 ± 1.06 | 26 ± 1.87 | 26 ± 1.95 | 25 ± 1.98 | 27 ± 1.94 | 28 ± 1.95 | 29 ± 1.97 |
| %Cumulative drug release (30 min) | 93.91 ± 0.12 | 93.34 ± 0.28 | 93.46 ± 0.34 | 93.54 ± 0.28 | 92.48 ± 0.15 | 92.75 ± 0.12 | 92.98 ± 0.05 |
Disclaimer/Publisher’s Note: The statements, opinions and data contained in all publications are solely those of the individual author(s) and contributor(s) and not of MDPI and/or the editor(s). MDPI and/or the editor(s) disclaim responsibility for any injury to people or property resulting from any ideas, methods, instructions or products referred to in the content. |
© 2024 by the authors. Licensee MDPI, Basel, Switzerland. This article is an open access article distributed under the terms and conditions of the Creative Commons Attribution (CC BY) license (https://creativecommons.org/licenses/by/4.0/).
Share and Cite
Alhamhoom, Y.; Kumaraswamy, T.; Kumar, A.; Nanjappa, S.H.; Prakash, S.S.; Rahamathulla, M.; Thajudeen, K.Y.; Ahmed, M.M.; Shivanandappa, T.B. Formulation and Evaluation of pH-Modulated Amorphous Solid Dispersion-Based Orodispersible Tablets of Cefdinir. Pharmaceutics 2024, 16, 866. https://doi.org/10.3390/pharmaceutics16070866
Alhamhoom Y, Kumaraswamy T, Kumar A, Nanjappa SH, Prakash SS, Rahamathulla M, Thajudeen KY, Ahmed MM, Shivanandappa TB. Formulation and Evaluation of pH-Modulated Amorphous Solid Dispersion-Based Orodispersible Tablets of Cefdinir. Pharmaceutics. 2024; 16(7):866. https://doi.org/10.3390/pharmaceutics16070866
Chicago/Turabian StyleAlhamhoom, Yahya, Thanusha Kumaraswamy, Avichal Kumar, Shivakumar Hagalavadi Nanjappa, Sanjana S. Prakash, Mohamed Rahamathulla, Kamal Y. Thajudeen, Mohammed Muqtader Ahmed, and Thippeswamy Boreddy Shivanandappa. 2024. "Formulation and Evaluation of pH-Modulated Amorphous Solid Dispersion-Based Orodispersible Tablets of Cefdinir" Pharmaceutics 16, no. 7: 866. https://doi.org/10.3390/pharmaceutics16070866
APA StyleAlhamhoom, Y., Kumaraswamy, T., Kumar, A., Nanjappa, S. H., Prakash, S. S., Rahamathulla, M., Thajudeen, K. Y., Ahmed, M. M., & Shivanandappa, T. B. (2024). Formulation and Evaluation of pH-Modulated Amorphous Solid Dispersion-Based Orodispersible Tablets of Cefdinir. Pharmaceutics, 16(7), 866. https://doi.org/10.3390/pharmaceutics16070866

